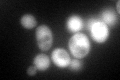
YCL035C
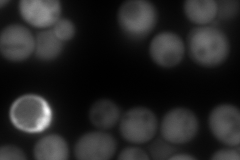
YCL035C
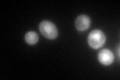
YCL035C

View description
Hydroperoxide and superoxide-radical responsive heat-stable glutathione-dependent disulfide oxidoreductase with active site cysteine pair; protects cells from oxidative damage
Localization:
Intensity:
Fold change:
Significance:
-
C’ GFP library in SD
cytosol97.66 -
N' NOP1pr-GFP in SD

cytosol290.729 -
N' TEF2pr-mCherry in SD
cytosol504.285 -
N' NATIVEpr-GFP in SD

cytosol81.3725 -
N' TEF2pr-VC and Cyto-VN in SD

#N/A0 -
C’ GFP library in SD+DTT

cytosol210.822.15Yes -
C’ GFP library in SD+H2O2

cytosol139.861.43Yes -
C’ GFP library in Starvation Media
cytosol338.663.46Yes -
C’ GFP library on the background of Pup2-DaMP

cytosol -
C’ GFP library on the background of CCT mutant

cytosol120.6821.23568No
